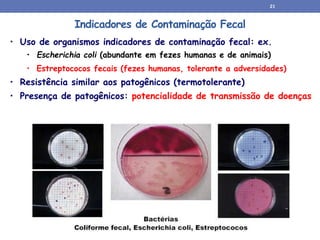
Indicadores de Contaminação Fecal
• Uso de organismos indicadores de contaminação fecal: ex.
• Escherichia coli (abundante em fezes humanas e de animais)
• Estreptococos fecais (fezes humanas, tolerante a adversidades)
• Resistência similar aos patogênicos (termotolerante)
• Presença de patogênicos: potencialidade de transmissão de doenças
21

O documento discute a caracterização da água, abordando os principais constituintes da água como sólidos dissolvidos, gases dissolvidos e compostos orgânicos. Detalha os parâmetros físicos, químicos e biológicos usados para caracterizar a qualidade da água, incluindo sólidos em suspensão, turbidez, cor, alcalinidade, nitrogênio, fósforo e micropoluentes orgânicos. Explica como esses componentes afetam a saúde e o meio ambiente

![Série NBR 10.004, 10.006, 10.007
IMPACTO AMBIENTAL E ASPECTOS LEGAIS
•A NBR-10.004/2004, dispõe sobre a definição e
classificação de resíduos sólidos
Classificados em: Classe I - perigosos, Classe II - não
perigosos (Classe II A – não inertes; Classe II B –
inertes)
• Resíduos de decantadores [resíduos sólidos]:
concentração de sólidos entre 30000 a 6000 mg/L
• Águas de lavagem de filtros [resíduo líquido]:
concentração de sólidos entre 50 a 300 mg/L.
• NBR-10.006 (Solubilização de Resíduos) – Ensaio de
solubilização para definição de material inerte.](https://image.slidesharecdn.com/caracterizacaodaagua-230214020223-15b93c7a/85/caracterizacao-da-agua-ppt-47-320.jpg)












![Reologia
“... estuda o escoamento e deformação da matéria, ou seja, descreve a deformação de um
corpo sob a influencia de tensões e remonta de postulações de Isaac Newton.“
fluidos newtonianos: tensão cisalhante tem relação direta e linear com o
gradiente de velocidade ou taxa de cisalhamento, descrita pela Lei de Newton
(Dentel, 1997).
τ= - μ.(dv/dy)
.
fluidos não-newtoniano: não obedecem a proporcionalidade direta entre a tensão
cisalhante e a taxa de cisalhamento ou deformação dv/dy, (Miki, 1998). coeficiente
de viscosidade é variável com a “taxa” de cisalhamento, o coeficiente de
viscosidade é definido como viscosidade aparente.
natureza tixotrópica da maioria dos lodos, ou seja, as características reológicas
são variáveis com o tempo, devido à tendência floculante dessas suspensões e
possíveis reações químicas diversas
• Equação de Einstein
η = ηo [1+ ø/2/(1- ø)2 ] = ηo (1+ 2,5 ø)
Em que: η, ηo = viscosidade da suspensão e solvente; Ø = fração
volumétrica ocupada por partículas.](https://image.slidesharecdn.com/caracterizacaodaagua-230214020223-15b93c7a/85/caracterizacao-da-agua-ppt-60-320.jpg)





![Coletas
Vazão
(L/s)
(I)
Água bruta
[SSxQab]
{kg/dia)
(II)
MPQ
[coef.x adição]
(kg/dia)
(III)
Água tratada
[SSxQat]
(kg/dia)
(IV) =
(I)+(II)-(III)
Produção total
de sólidos
(kg/dia)
Massa
grama de
sólidos/m3
água tratada
3 540 728 351 105 974 21
4 520 569 547 79 1038 23
5 500 1655 704 135 2224 51
6 530 490 240 46 684 15
7 520 571 269 0 840 19
8 550 360 240 0 599 13
9 480 236 181 0 417 10
Média 520 658 362 52 968 22
Produção global de sólidos
Carga de sólidos produzida diariamente na ETA 968 kg ou 0,96 toneladas
Contribuição proveniente da adição de produtos químicos 362 kg (37 % )](https://image.slidesharecdn.com/caracterizacaodaagua-230214020223-15b93c7a/85/caracterizacao-da-agua-ppt-66-320.jpg)
![Testes de correlação SS = b.T
CORNWELL (1987): b entre 0,7 e 2,2
RESULTADOS: SS = 0,671.T (r2=0,796)
Análise de regressão múltipla Produção diária de sólidos
CORNWELL (1987): PL = Q(4,89.DAl + SS + A).10-3 (kg/dia)
DAl = Al em mg/L
RESULTADOS: Psól. = 44.SS + 0,26.DSA + 63,765 (kg/dia)
DSA = [Al2SO4.14H2O] em kg/dia](https://image.slidesharecdn.com/caracterizacaodaagua-230214020223-15b93c7a/85/caracterizacao-da-agua-ppt-67-320.jpg)




